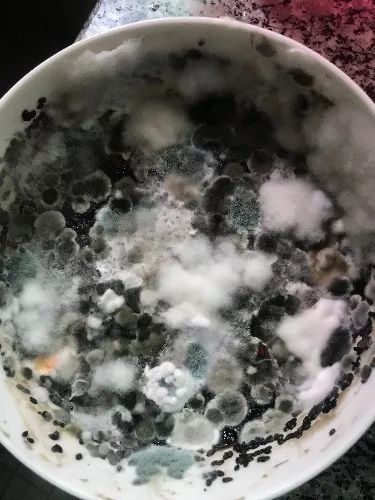
义乌一少妇千方百计花千把块钱买了阿胶，女人没这本事怎能做老婆

网友 @战乌云 在稠州论坛APP上发帖:女人不败家,怎么做人家老婆
这就是老婆千方百计要买的阿胶,花了千把块钱,吃了一部分,剩下这至少还有五、六百块钱的份量,到最后全长白毛了!
你猜她怎么说,就百把块钱。 我提示她共千把块钱你吃了小一半,这里是多少钱?她不好意思地笑了! 我也只能笑笑,毕竟人比钱重要多了,您说是不是?
老婆回复说,开始吃了一段时间,后来身体不舒服才停下来没吃。没有经验以为放冰箱冷藏不会坏,今天拿出来装备吃才发现坏了。
女人的事,没有大小事,只有大事
网友热评
@我来看评论:这不是钱的问题,这是懒!得治!这么说不算挑事吧?
@WUZHANG:买来比吃了的效果好,心理作用
@北苑金牛鸡祥:等着跪搓衣板
@晴天雾霾:女人吃这些对身体好,浪费也不是有意的,总比男人抽烟烧钱的好
@零下8度:你老婆应该是想种植阿胶吧 以后长出来割着吃 跟青菜一样 看着发酵的挺好 被你丢了可惜了
@媚者无疆:我老婆也是这样子,有的一拼
@还好吧2013:我家4800元三溪堂熬的膏方吃了三次太甜了就丢在那里,已经2年了。早已变质,现在还丢在冰箱里。
@榕城:对的,我第一次也是这样熬起来,吃太不方便,说实话也是放到长毛才扔掉的,后来就自己切片了
@真不卖茶:有啥好吐槽的?自己选的老婆就算再败家,你也得认……
@东方狼:老婆不败家,老公赚钱有何用?
@江边走高跷:拉动内需、跟老美干仗,全靠你们了
有人说,只要花钱不是大手大脚,有节制有计划,那么会“败家”一点地女人反而更幸福!
因为……
1、有一点败家的女人往往经济更独立,有花钱的欲望就会有赚钱的动力!

2、有一点败家的女人大都懂得投资自己,时刻保证自己与时俱进。


3、有一点败家的女人更吸引老公,她们自信优雅,也更爱自己。


4、有一点败家的女人情商更高,朋友也更多。


5、有一点败家的女人更加注重生活品质,更有情趣。


除此之外她们也对新鲜事物总会充满浓厚的兴趣,时不时会倒腾些新鲜东西回来装饰家里。
6、有一点败家的女人,心态更好,更积极乐观。

7、有一点败家的女人,养育出来的孩子不会斤斤计较!

8、最重要的是:有一点败家的女人,老公才会更有赚钱的动力!

你怎么觉着?你或你家老婆“败家”吗?留言说说你的看法~
来源 | 稠州论坛APP、亲子派
转载请注明出处义乌稠州论坛(ywczlt)